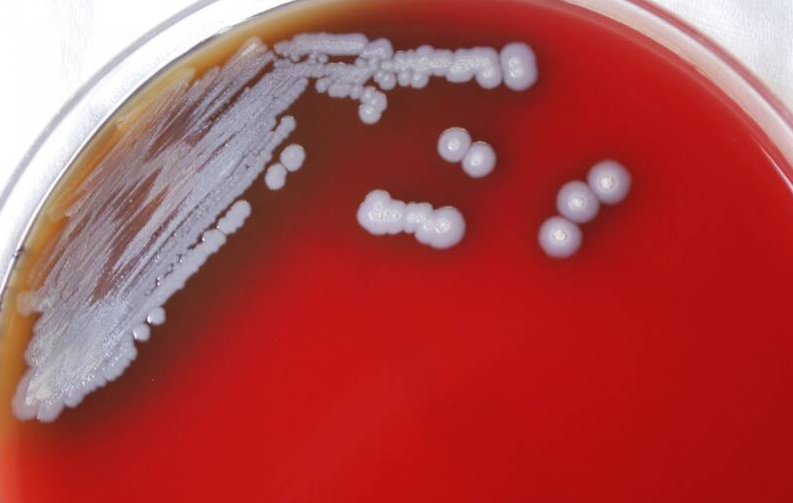
Бактерии с летальностью 50% появились в Мексиканском заливе, CDC США подтвердил, что 3 человека заразились

Бактерии с летальностью 50% появились в Мексиканском заливе, CDC США подтвердил, что 3 человека заразились
07.06.2023 17:57
[Мгновенные новости/Подробный отчет] Центры США по контролю и профилактике заболеваний (CDC) подтвердили, что на побережье Мексиканского залива появилась опасная бактерия с летальностью 50%, которая может вызывать «мелиоидоз» после инфекция человека Лечение может привести к летальному исходу. Он был внесен в список CDC как эндемическое заболевание, и он предупредил, что случаи заражения могут происходить от Техаса до Флориды.
Согласно отчету «UPI» , с июля 2020 года CDC США выявили 3 случая заражения «Burkholderia pseudomallei» (Burkholderia pseudomallei) в штате Миссисипи. CDC заявил, что бактерии в основном появляются в Юго-Восточной Азии и северной Австралии. Бактерии могут передаваться людям и животным через контакт с загрязненной почвой и водой, а заражение человека может также вызывать редкий и смертельный мелиоидоз.
Последний случай был обнаружен в Миссисипи в январе этого года. Ранее, в июле 2020 года и мае 2022 года, случай был обнаружен в том же штате и округе. На данный момент инфицировано 3 человека. В связи с этим эпидемиолог CDC Джулия Петрас (Julia Petras) заявила, что мелиоидоз в настоящее время рассматривается как эндемическое заболевание в США, и случаи заражения могут происходить от Техаса до Флориды.
Петрас также упомянул, что, поскольку у большинства людей, подвергшихся воздействию этого микроба, нет симптомов и в организме вырабатываются антитела, не исключено, что заразилось больше людей, все выздоровели. Кроме того, то, как бактерии распространяются из теплых и влажных тропических стран на побережье Мексиканского залива США, по словам Петраса, может быть вызвано изменением климата, но подробные причины еще предстоит изучить специалистам.
Согласно другому отчету, у пациентов, страдающих мелиоидозом, обычно наблюдаются такие симптомы, как лихорадка, боль в суставах и кашель, и эта бактерия очень смертельна для людей с диабетом, хроническими заболеваниями почек, заболеваниями легких и людей с низким иммунитетом, если только не будет проведено раннее лечение пациентов. А использование правильных антибиотиков может избежать осложнений пневмонии, заражения крови и даже смерти.


